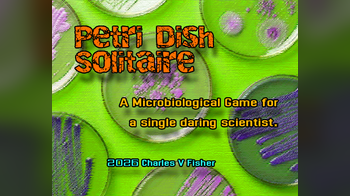

Physical game Devlogs
Hello! Backstock physical copies of INFINITE REVOLUTION are now available for purchase via Indie Press Revolution. Find them here: https://www.indiepressrevolut...
Today is the day! Early access is officially over, and the game has been updated to V1.0! If you’re looking for physical copies, get ‘em here: https://table...
That's it! The Magic of Inventorying Kickstarter is almost over. You have until April 28th at 5pm BST (London-time), for the US that's 12pm (Eastern time), to j...
Hello! A fully revised edition of Troves is now available. This version is not compatible with the old as almost all rules have been modified in some way. I've...
It's happening folks. Brimstone and Lead minis are inbound. @elmutanto.bsky.social is handling the first set of modular space nuns and oversize guns. https://cu...
Hello folks! It’s been a while! Firstly, some bookkeeping. As you may have noticed, Ironbound Shadows is currently on sale! This module will be on sale from A...
1 file
Fixed some small typos in the PDFs...
3 files
Draw Steel - Resist the tyranny of UNISOL, and confront the mighty herald of XXAXX in this quest for 7th-level heroes!
I am going to start putting out a post every week diving into the design inspiration and development behind The Curse of Planet X . To start with, I should prob...
Agora Magi Cítrico também pode ser adquirido no site da RPGpédia!! Parte dos meus jogos agora também estão disponíveis na RPGpédia, KASHU!, Magi Cítrico...
Agora Fungi Bello também pode ser adquirido no site da RPGpédia!! Parte dos meus jogos agora também estão disponíveis na RPGpédia, KASHU!, Magi Cítrico e...
How to Lie with Maps by Mark Monmonier is an fun read on the biases and imperfections that come with map making. You should read it, and then you should assume...
Hey Gnomies! I have recently updated the dungeon. Here is a list of what has changed: [General] Fixed alignment issues [Map] Thickened colored lines on map Upda...
4 files
Hey everyone, if you’ve been enjoying my games, I wanted to let you know that Grim Dungeons and Ancient Lore is 50% off for a short time. If you’ve looked a...
Hey everyone, if you’ve been enjoying my games, I wanted to let you know that Grim Dungeons and Ancient Lore is 50% off for a short time. If you’ve looked a...
Hey everyone, if you’ve been enjoying my games, I wanted to let you know that Grim Dungeons and Ancient Lore is 50% off for a short time. If you’ve looked a...
The 1.1 version of the rules makes some subtle changes in font formatting and rules ordering based on playthrough feedback during and immediately after Ostara...
2 files
Hey Dungeoneers, Grim Dungeons and Ancient Lore is 50% off for a short time. If you’ve looked at it before and moved on, this is a good moment to return. The...
Hey, folks. As a heads up, the Agency of Narrative Intrigue and Mystery (A.N.I.M.) – publishers of Eureka: Investigative Urban Fantasy , as well as the forthc...
[FR] 8 Scénarios sortis des Abysses 8 Histoires sordides 8 Aventures extraordinaires Pour soirées intrépides et adultes consentants. Le dernier receuil de sc...
3 files
Lots of exciting new stuff in this one! Text Changes Added Pressure - a new dynamic that should make higher difficulties feel more, well, difficult, while still...
3 files
Із версії для екрану загадковим чином пропала таблиця аспектів. Ну як "загадковим" - нас...
1 file
Age of Al-Azrad has been added to Cthulhu Forever. Only last did week I proudly announce that all the Ages had been supported only to realise that a new one had...
Hello people, it's been a while! Thesis is in full swing and lots of things have been going on. So I'm here to provide some updates about what I've been reading...
Ya tenéis unas tablas bien chulas para vuestras cuevas y para vuestros personajes prehistóricos. Porque, ¿A quien no le va a gustar tener un personaje que no...
1 file
Update en V5_3 de la beta. Les modifications ne changent pas le jeu en lui-même : Ajout d'une étape type Session 0 pour l'accessibilité dans la section Créa...
1 file
edited some sections for clarity, added some info where it was ambiguous, changed the margin size to reduce page count...
1 file
-Added new rules for Quickdraws, Clashes, and Binds -Updated properties for Arquebus in items list -Updated the Ability of the Bridge Samurai -Updated the items...
1 file
Hey folks! The inimitable Faan has made a major update in the Codex for this quest. I know not many of you have checked out the quest in the Codex, but if you h...
I’m hard at work (or hardly working?) at the second Hexposition Notebook zine. Here’s a preview of one of the spreads, on feudal realms. Here I define some...
Meet the Hero of The Frozen Woods—and the horrors waiting in the frost. Hello everyone, In my last post, I introduced the "what" of my new 2d6 Dungeon expansi...
Heya there all, I'm hard at work completing Mission 2 and it's a big one. It's the largest of the original 3 by far, and it's actually so big I'm splitting it u...
2 files
Hello friends and fellow adventurers! I've updated Scott's KISS GM Emulator to include a Scene table that helps you get started with your first, or new secne. I...
2 files
Hey everyone, The coming soon page for The Curse of Planet X is finally live. I've been putting a lot of hours into this, so it feels good to actually have a pl...
Il s’agit d’un jeu de rôle sur table d’enquête sombre se déroulant dans le village maudit de Brumeval, mêlant mystère, tension et choix significatifs...
1 file
Hello wrestling fans - at long last, I've completed the Gimmick sheet redesign to adequately support the gnarly new Gimmick artwork that Lukasz Kowalczuk did as...
2 files
Added a text file with link to the Virtual Tabletop. The file contains a link to the Google Sheets VTT as well as instructions for using it. You will need to au...
1 file
1 file
A collection of odds & ends for Daggerheart
he Shadow Within is now available on itch.io. This is a dark investigative tabletop RPG set in the cursed village of Brumeval, blending mystery, tension, and me...
1 file
After posting the previous version to Reddit for the first time, I got some interesting feedback here and here . First of all, why the heck was I calling the "e...
1 file
Minor formatting change, grammar fixes, and a list of inspirational material added to the rear center panel...
1 file
I've started updating all the StoryGuider adventures (and adding some totally new ones) by swapping in professionally made art, updating the formatting, and con...
4 files
Star Solo Update Coming on June 27th! Star Solo will get an update coming on free RPG day, June 27th! This update is a long time coming. A quick history of how...
Mater Dolorosa is my first TTRPG. I have been wanting to make my own TTRPG for a long time, and the 3rd Breathless Jam was perfect for this. Breathless SRD is f...
6 files
Attention cavepeople, a new update is out for the newly-renamed 28 MILLIMETERS B.C.! Here are the main notes: New Name: 28 MILLIMETERS B.C. I've renamed this pr...
1 file
The VTT Assets file was updated. One missing map was added...
Largely clarifications, fixes, and some small balance changes. Contributors: Tulip, dog Administrative Changes: Added dog to the contributors in the main rules...
1 file
I'm pulling the trigger and releasing the first part of my system today...
1 file
I hate writing every single one of these i really do. I hate looking at this screen. Anyways go look at my pnet forum page if you want to know more but basicall...
6 files
Un gioco serio ha visto la luce, nella sua forma finale, circa un anno fa. Scelgo la data di oggi per questo postmortem, poiché sono consapevole che alcune cos...
Hoy os traigo un fragmento de lore del mundo. Ya había publicado anteriormente en bluesky un primer borrador de esta pieza de lore que ilustra el nacimiento de...
Loading more posts...